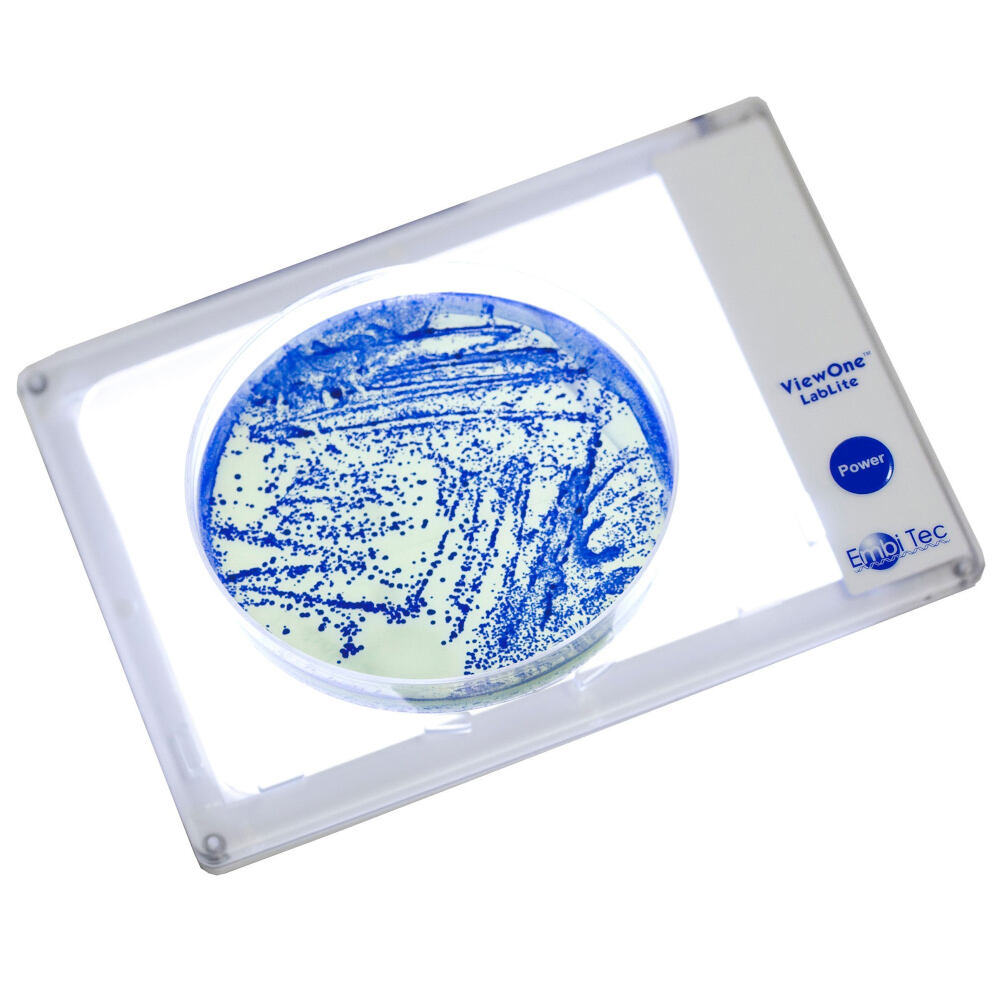

Enlighten your samples with the compact, lightweight, and portable light box!
Water resistant, ultra-compact light box brilliantly illuminates your samples and provides an additional backlight to your imaging system or microscope. The built-in retainer for Petri dishes, agar plates, and 96-well plates hold your samples in place. Simply plug in and turn on the LabLite and place your plate or use the 96-well plate template (included) to see your sample with a new light! White LEDs with 3 selectable intensities provide illumination that is right for your sample and your room.
Don't lug around a bulky light box! The ViewOne™ LabLite just slightly bigger than your smartphone and weighs only 160 g (5.6 oz)!
Better visualization for a wide range of applications:
- 96-well ELISA plates & 384-well plates
- Bacterial plates - see more as you pick your colonies
- Coomassie Blue stained gels
- Micro-dissection
- Hemagglutination assays (HA or HI)
- Zyogram gels
- Cell culture
| Dimensions | 11.5 cm (W) x 17 cm (L) x 0.5 cm (H) |
| Weight | 160 g |
| Light Source | White LEDs |
| Operating Voltage | 100V-240V. Interchangeable input plugs included for international compatibility |